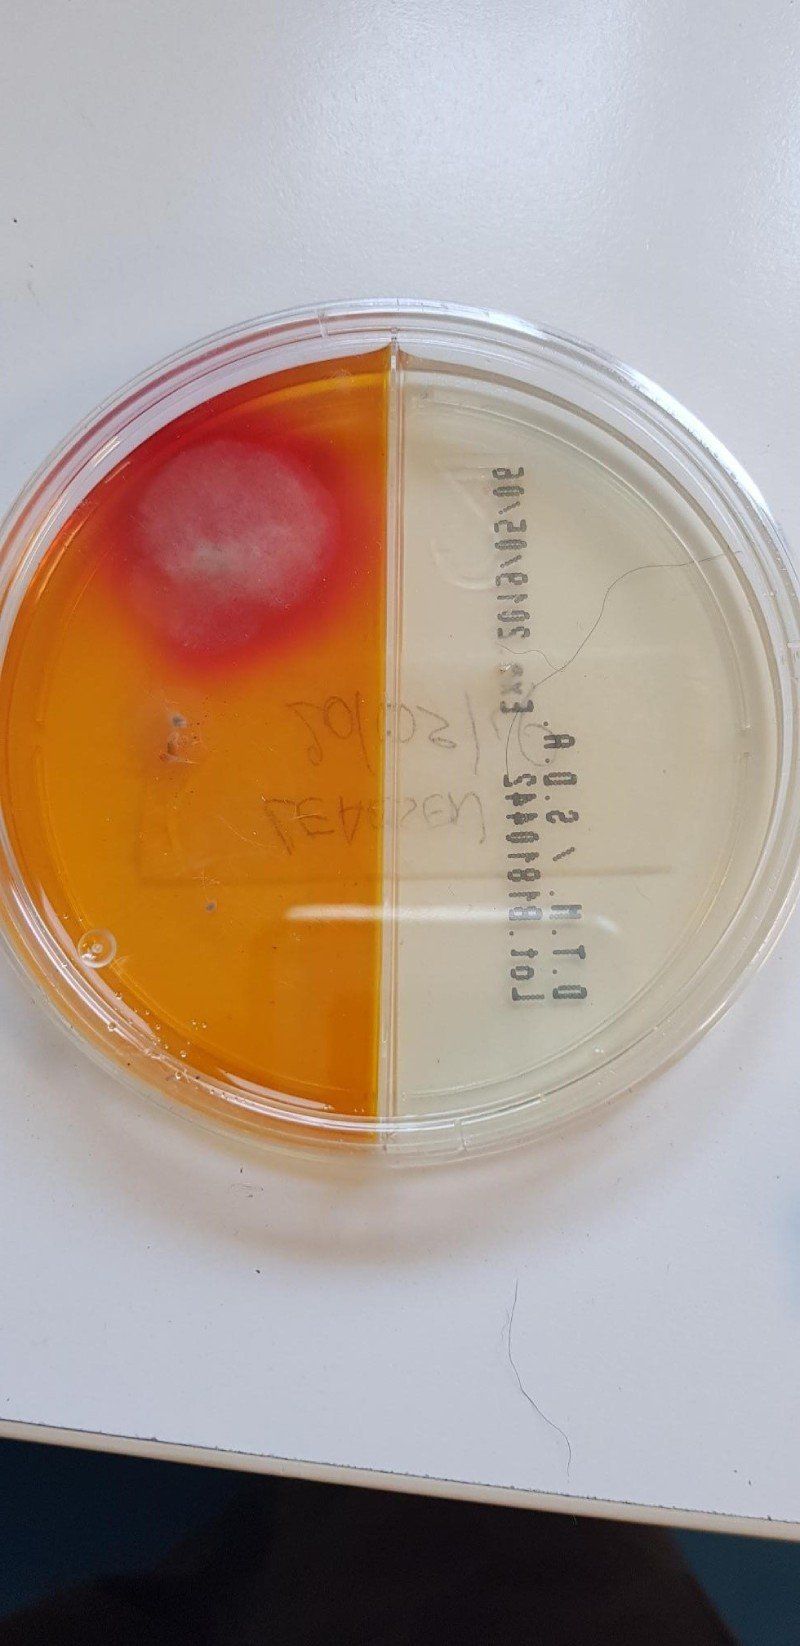
Campione per analisi

Ambulatorio e laboratorio veterinario a Siena
Cerchi un ambulatorio veterinario a Siena dotato delle migliori strumentazioni? Prenota un appuntamento con noi al Centro Veterinario Montarioso! Siamo a tua disposizione con tutto ciò che occorre per prenderci cura delle necessità di cani e gatti.
I servizi del centro veterinario
Il nostro ambulatorio veterinario di Siena collabora con i migliori laboratori italiani: in questo modo noi del Centro Veterinario Montarioso riusciamo ad eseguire esami e diagnosi per immagine approfonditi, tra cui anche gli esami di radiologia digitale e le ecografie.
Ad orari prestabiliti e previo appuntamento, il nostro ambulatorio veterinario collabora con specialisti in medicina interna e diagnostica per immagini, chirurgia generale, dermatologia, oftalmologia.
Le nostre veterinarie esperte
Al Centro Veterinario Montarioso di Siena opera uno staff di liberi professionisti.
Il personale del nostro ambulatorio veterinario è giovane, dinamico e tutto al femminile:
- Dott.ssa Cecilia Sisi
- Dott.ssa Elisa Brogi
- Dott.ssa Michela Fontani
- Dott.ssa Caterina Borgianni
Gli spazi della clinica veterinaria
Il Centro Veterinario Montarioso di Siena si è completamente rinnovato e offre un ambiente composto da:
- una sala d'attesa;
- tre sale visita;
- una sala operatoria attrezzata;
- un laboratorio per poter effettuare analisi di base;
- un radiologico diretto per poter effettuare radiografie
- all'esterno, ampio parcheggio e un'area verde dove passeggiare con i cani.
Precisiamo che il personale del nostro ambulatorio veterinario segue con il massimo scrupolo le norme d'igiene previste dalla normativa vigente.
Al Centro Veterinario Montarioso puoi effettuare dalle radiografie agli eco-cardiogrammi prenotando